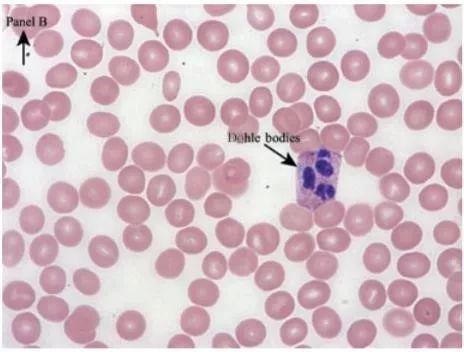
免疫性血小板减少症真不能治了吗,免疫性血小板减少症是不是很可怕

作者:爱花生
本文为作者授权医脉通发布,未经授权请勿转载。
导读
患者因血小板减少就诊,其他血液检查无明显异常,诊断为ITP,给予糖皮质激素等相应治疗后却未见疗效。是何原因呢?
2013年European Journal of Haematology报道过一个病例,一个21岁的女性,从两岁开始无明显诱因出现血小板减少,基础血小板值在5~15×109/L,却并没有出血症状。营养性、病毒感染和自身免疫性因素均被排除,凝血功能筛查及多次骨髓活检也没有发现异常,最终被诊断为免疫性血小板减少症(ITP)。给予糖皮质激素、静脉丙种球蛋白、抗-D免疫球蛋白、利妥昔单抗等治疗后却均没有明显疗效。
2018年,中国小儿血液与肿瘤杂志报道了一个相似病例,一个6岁男童,因发现血小板减少5年入院,初诊时血小板值44×109/L,无出血表现,血生化、凝血常规、自免全套等检查均无异常,诊断为ITP,予糖皮质激素及间断应用升血小板药物治疗,血小板无明显回升。
以上2例患者均因血小板减少就诊,其他血液检查无明显异常,诊断为ITP,给予糖皮质激素等相应治疗后却未见疗效。是何原因呢?
后来,在女性患者外周血涂片中发现有巨大血小板和中性粒细胞包涵体,基因检测发现31号外显子存在错义突变c.4336T>C。在男童患者外周血涂片中发现巨大血小板,基因测序结果显示MYH9基因的第17号外显子存在错义突变c.2105G>A。最终,两名患者均被诊断为一种先天性血小板减少症---- MYH9相关疾病(MYH9-RD)。

MYH9相关疾病(MYH9-RD) 被定义为一种生后即有大血小板性血小板减少和白细胞包涵体,并可能在生命任何阶段合并进展性肾病、耳聋或白内障的常染色体显性遗传性疾病,由编码非肌球蛋白重链IIA (NMMHC-IIA)的MYH9基因突变引起,是先天性血小板减少症中最常见的类型之一,包括了过去的May-Hegglin 畸形、Sebastian 综合征、Fechtner 综合征和 Epstein 综合征。NMMHC-IIA是肌球蛋白超家族的成员之一,在所有造血细胞类型中均有表达,在细胞运动性、细胞分裂、趋化、吞噬和维持细胞形态等方面发挥重要作用。同时也存在于肾脏、耳蜗内和晶状体中。
MYH9-RD的临床表现
出血:与血小板数目有关,患者可有所谓的出血综合征,如易出现淤斑淤点,月经过多和鼻衄或牙龈出血。部分患者没有临床症状,往往在外伤后或手术前查血才发现血小板减少。
肾脏受累:约30% 患者有肾脏受累,可在30岁前出现血尿、蛋白尿,且有70%肾脏受累者最终进展为肾衰竭。
白内障:有超过10%的患者可有晶状体混浊。
听力缺陷:进行性听力受损是MYH9-RD最常见的血液系统外损害,约有60%的患者受累,表现为双侧感音性听力损害,发病早晚与基因突变类型有关,儿童或者青春期发生听力受损多于30岁前发展为耳聋。
MYH9-RD的实验室检查
血小板:
体积:自生后即出现的巨大血小板,在外周血涂片中清楚易见,而自动血细胞检测仪主要通过血细胞大小辨识血细胞,会把这种巨大血小板计为红细胞,而导致平均血小板体积和血小板数目都低于实际值。
数目:个体差异较大。由于普通检测仪测定血小板数多低于实际,显微镜检是检测血小板数目、进而评估出血风险的必要检测手段。
白细胞:
外周血涂片可见中性粒细胞内包涵体,即杜尔样小体((Dohle bodies),是胞浆 NMMHC-IIA 聚集所形成,所有MYH9-RD 患者中性粒细胞中都可以经免疫标记法探得,是重要的确诊指标。
MYH9-RD的治疗
主要为防止出血,输注血小板提升血小板数目,促血小板生成素受体激动剂(艾曲波帕)等,而针对ITP的治疗如糖皮质激素、丙种球蛋白、免疫*制剂抑**及脾切除等基本无效。
MYH9-RD在临床上少见,并且极易被误诊为ITP,对于生后即出现血小板少,病史长,常规治疗效果不佳的患者,尤其当合并耳聋、肾损害和(或)白内障时,应怀疑本病可能,外周血涂片是诊断本病的简单有效的手段。
参考文献:
1.Skiver B M , Patel S B , Bose P . It is not always immune thrombocytopenia: a case of MYH9-related platelet disorder caused by a novel mutation[J]. European Journal of Haematology, 2013, 91(2):191-192.
2.Balduini A , Raslova H , Buduo C A D , et al. Clinic, pathogenic mechanisms and drug testing of two inherited thrombocytopenias, ANKRD26 - and MYH9 -related diseases[J]. European Journal of Medical Genetics, 2018.
3.Ban B H , Shah V . MYH9-Related Thrombocytopenia[J]. Mayo Clinic Proceedings, 2017, 92(7):1169-1170.
4.艾奇,陈森. MYH9相关疾病的新进展[J]. 国际医药卫生导报,2019,25(11):1832-1836.
5.李运玲,徐学聚,等. MYH9基因突变相关的遗传性血小板减少症1例并文献复习[J].中国小儿血液与肿瘤杂志,2018,23(6):297-300.